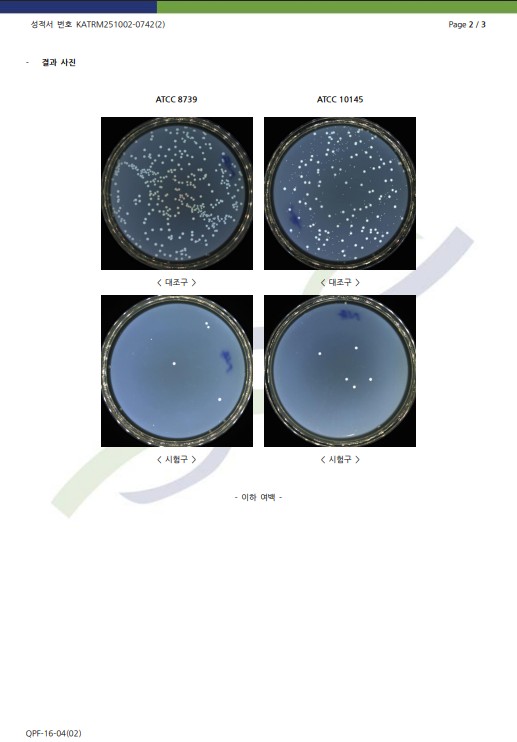
무좀균2.jpg

녹농균(무좀균). 대장균 98% 이상 사멸 시험성적서
페이지 정보
작성자 관리자
조회 190회 작성일 26-01-20 17:23
조회 190회 작성일 26-01-20 17:23
본문
녹농균(무좀균). 대장균 98% 이상 사멸 시험성적서입니다.
아래 사진을 참조하세요

- 이전자료6대 화학제품 불검출 및 4대 탈취시험 성적서 26.01.20
- 다음자료8대 중금속 및 불검출 및 31화학 시험 불검출 성적서 26.01.20
